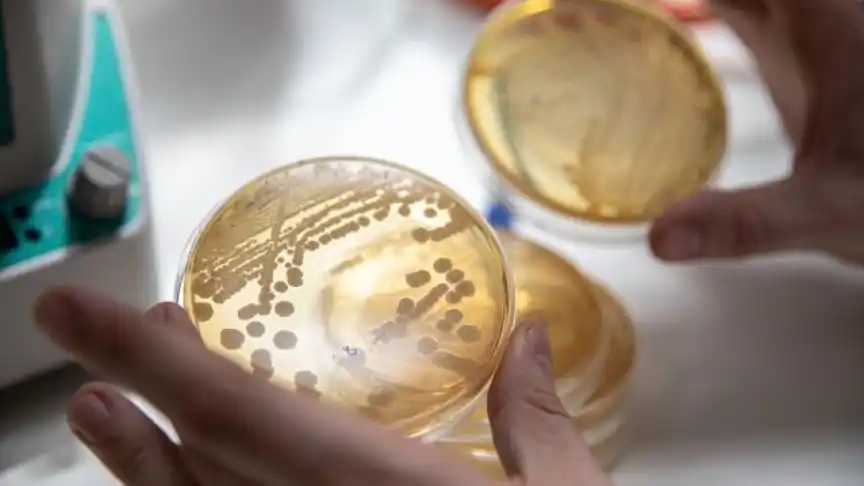
758934121_232664942_864x486

La dieta que podría evitar 15 millones de muertes al año (y de paso salvar al planeta)
¿Es posible salvar el planeta con una dieta? Es lo que intenta descubrir una comisión de científicos que trabaja desde el 2019 en la denominada Dieta de Salud Planetaria